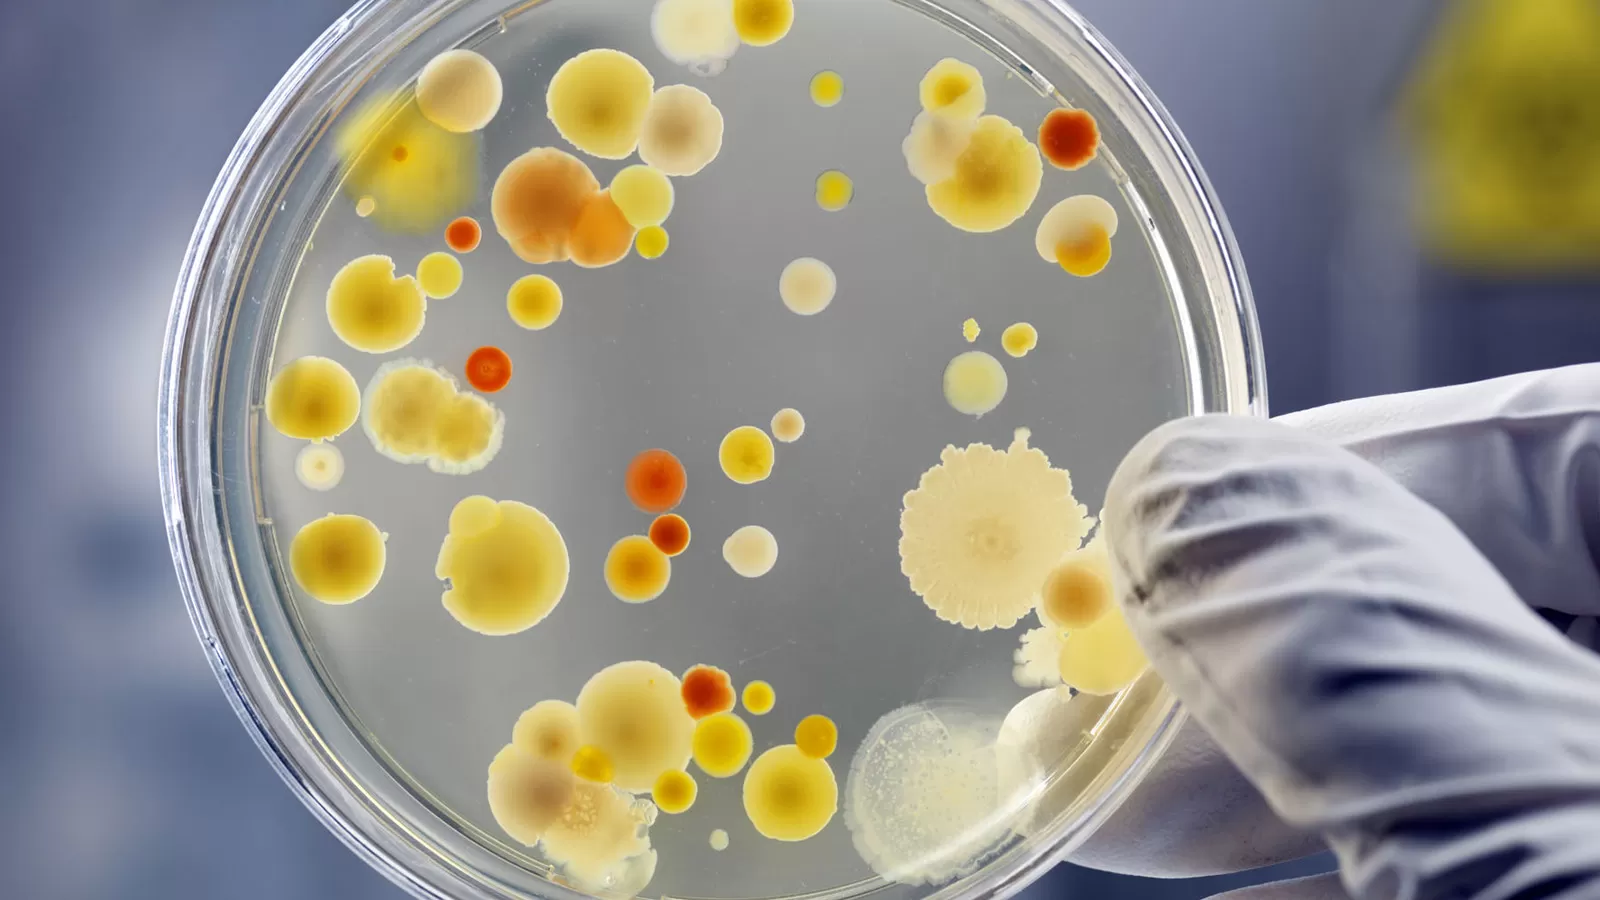

Laboratorio Analisi Ambientali
Il nostro laboratorio di analisi ambientali si avvale di strumenti diagnostici moderni e metodiche analitiche riconosciute. È sottoposto al sistema di accreditamento ACCREDIA in conformità alla norma europea UNI CEI EN ISO/IEC 17025, con numero di accreditamento 0252.
Tutti i processi e l’organizzazione del Laboratorio BIOKEMIC si basano su rigorose procedure di qualità che garantiscono l’affidabilità del risultato analitico. La preparazione del personale, unitamente a strumentazione all’avanguardia, hanno favorito negli anni lo sviluppo di un formidabile staff di professionisti che ha accompagnato il costante allargamento dei campi di indagine.
Il Laboratorio si è fin dalle sue origini specializzato nella ricerca dei determinanti sulla qualità delle acque e dei processi di depurazione. Con l’evolversi della normativa ambientale anche BIOKEMIC ha allargato il proprio ambito di specializzazione.
Contattaci
Per informazioni ancora più dettagliate e casi specifici, il nostro Servizio Clienti è a tua disposizione!